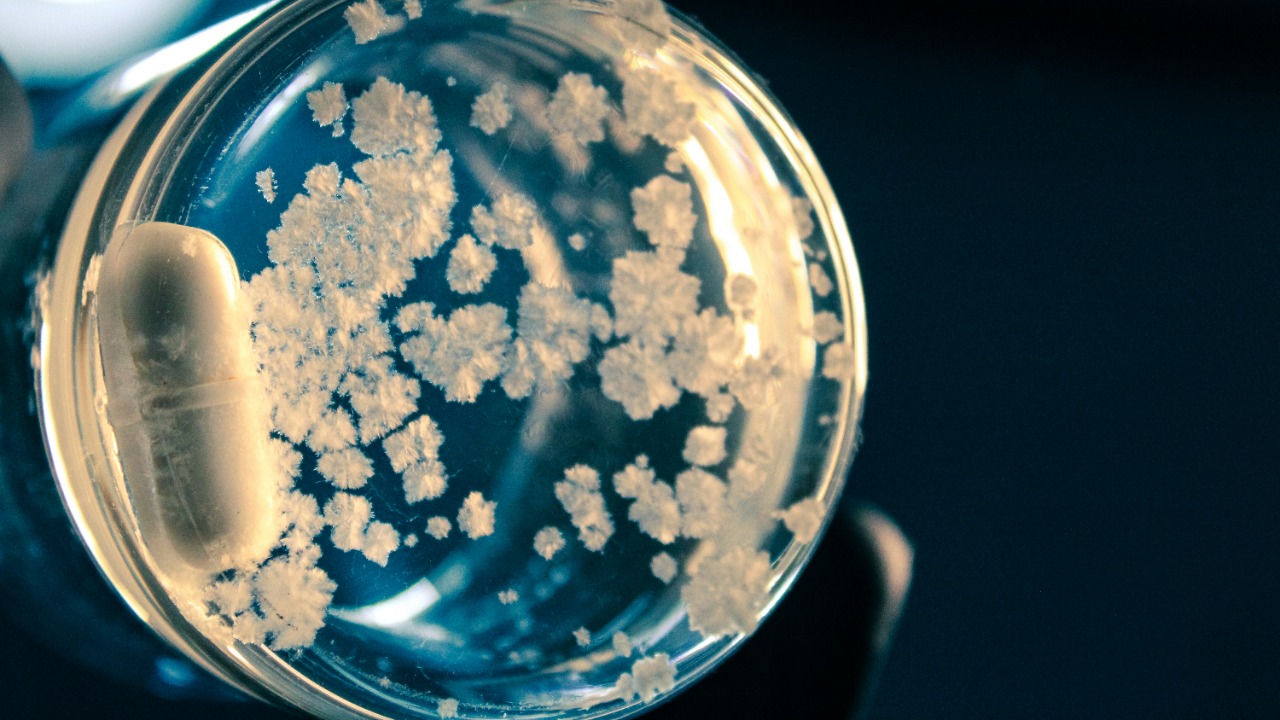
scentspiracy/Unsplash

In recent years, scientists have discovered bacteria capable of breaking down plastic waste, offering a promising solution to one of the world’s most persistent environmental challenges. These bacteria, often referred to as “plastic-eating bacteria,” have the potential to revolutionize how we manage plastic waste and its impact on the planet. The fascinating world of these microorganisms plays a crucial role in combating plastic pollution.
The Science Behind Plastic-Eating Bacteria
Plastic pollution is a pervasive problem, with millions of tons of plastic waste entering the environment annually. This waste persists for hundreds of years, disrupting ecosystems and harming wildlife. The sheer scale of plastic pollution has prompted the urgent need for innovative solutions to address this growing crisis.
The discovery and identification of plastic-eating bacteria have provided a glimmer of hope. Initially found in natural habitats like soil and water, these bacteria possess unique biological mechanisms that enable them to digest plastic. By breaking down the complex polymers found in plastics, they convert them into simpler, harmless compounds.
Among the key species involved in plastic degradation is Ideonella sakaiensis, known for its ability to break down polyethylene terephthalate (PET), a common type of plastic. These bacteria utilize specific enzymes to target and degrade plastic, showcasing their potential in reducing plastic waste.
Mechanisms of Plastic Degradation

The enzymatic processes involved in breaking down plastics are central to the functionality of plastic-eating bacteria. These bacteria produce enzymes such as PETase and MHETase that specifically target plastic polymers. Once the enzymes attach to the plastic, they begin to break the long chains of polymers into smaller, more manageable molecules.
Several environmental factors influence bacterial plastic degradation. Conditions such as temperature and pH levels can significantly affect the efficiency of these processes. Furthermore, advances in genetic modifications are being explored to enhance bacterial capabilities, potentially increasing the speed and specificity of plastic degradation.
However, challenges remain in optimizing these processes for industrial applications. Scaling bacterial degradation to meet industrial demands is a complex task, and researchers are exploring potential solutions to overcome these obstacles, such as improving bacterial resilience and efficiency.
Applications and Benefits

The potential industrial applications of plastic-eating bacteria are vast. By integrating these bacteria into waste management systems, they could significantly reduce the volume of plastic waste in recycling facilities and landfill sites. This integration would not only aid in managing existing waste but also pave the way for more sustainable waste processing systems.
Environmentally, the use of bacteria to manage plastic waste could substantially reduce the ecological footprint of plastic pollution. This approach not only promises cleaner ecosystems but also reduces our reliance on fossil fuels traditionally used in plastic production.
Economically, employing bacteria for large-scale waste management could prove cost-effective. New market opportunities may arise from biotechnological advancements in plastic degradation, potentially revolutionizing how industries approach waste management and recycling.
Current Research and Developments

Recent breakthroughs in bacterial plastic degradation have been significant. Current studies have highlighted the potential of these microorganisms in reducing plastic waste. Collaborations between academic institutions and industry partners are crucial in advancing this field.
Genetic engineering and synthetic biology are playing pivotal roles in enhancing bacterial efficiency and specificity. By genetically modifying bacteria, researchers aim to create strains that are more effective at targeting specific types of plastics. However, this approach raises ethical considerations and regulatory challenges that must be addressed.
Looking forward, future directions include ongoing projects and pilot programs aimed at global implementation. The potential for widespread adoption of plastic-eating bacteria is promising, with global collaboration being key to its success.
Challenges and Considerations

Despite their promise, the reliance on plastic-eating bacteria presents certain limitations and risks. Introducing these bacteria into new environments could pose ecological risks, and their widespread use could lead to unintended consequences that need careful monitoring.
Balancing technological innovation with environmental safety is paramount. It’s crucial to implement regulations that ensure the safe application of bacterial technologies while maintaining biodiversity and ecosystem balance.
Ultimately, a multifaceted approach to plastic waste management is essential. While plastic-eating bacteria offer a promising tool, they should be part of a broader strategy that includes continued development of complementary technologies and policies. By combining various solutions, we can more effectively address the global challenge of plastic pollution.
